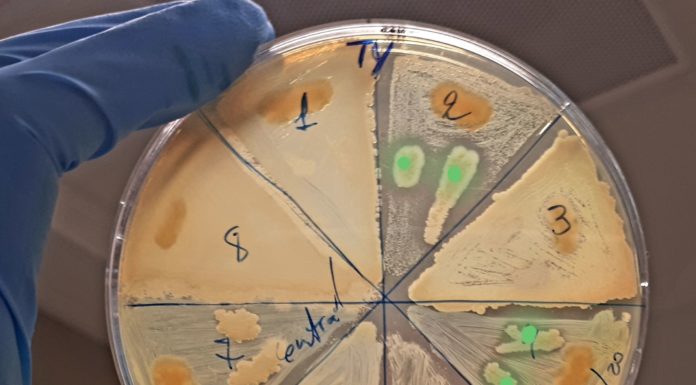
Cervelli al Sud, da Siviglia a Napoli per lo studio di microorganismi marini

Home ITALPRESS con il SUD: Fare impresa sociale nel Mezzogiorno
Brains to South è il bando promosso dalla Fondazione CON IL SUD, grazie al quale ricercatori stranieri o italiani, che svolgevano la loro attività da almeno 3 anni all'estero o nel Centro - Nord stanno avendo l'opportunità di condurre...
ROMA (ITALPRESS) - Walter Tarantino, 37 anni ha trasferito dal Politecnico Federale di Zurigo - ETH al Dipartimento di Fisica dell'Università di Cagliari le sue ricerche sulle tecnologie alternative a quelle basate sul silicio. In particolare segue lo studio...
ROMA (ITALPRESS) - Simone Dario Scilabra, 37 anni, è nato e cresciuto in Sicilia. Ha studiato, vissuto e lavorato all'estero molti anni. Al centro delle sue ricerche, è da sempre l'artrosi. 'Una patologia - spiega - per cui...
ROMA (ITALPRESS) - NCO - "Nuova Cucina Organizzata" è "anche" una pizzeria a Casal di Principe, peraltro ai primissimi posti nelle più gettonate classifiche online. Ma è soprattutto un'attività imprenditoriale innovativa, un laboratorio di inclusione sociale con il valore...
ROMA (ITALPRESS) - Villino Geraci, ad Altavilla Milicia in provincia di Palermo, è un bene confiscato a un imprenditore affiliato a Cosa Nostra che da fortezza inaccessibile e circondata da mura è diventata un Centro Culturale Polivalente con attività...
ROMA (ITALPRESS) - In una villa confiscata nella zona Santo Spirito di Bari sono stati realizzati un b&b con american bar, bistrò e spazio per eventi. La struttura, inoltre, ospita 6 ragazzi migranti in regime residenziale o semi...
ROMA (ITALPRESS) - La cooperativa Verbumcaudo sta germogliando dove prima dominava la mafia e, grazie ad una nuova iniziativa progettuale sostenuta da Fondazione con il Sud e Fondazione Peppino Vismara e realizzata da Consorzio Agrietica in partenariato con i...
ROMA (ITALPRESS) - Un nuovo protagonismo del terzo settore che permetta alle comunità di riappropriarsi dei beni confiscati alla criminalità organizzata, di valorizzare questo patrimonio attraverso un uso collettivo e di metterlo al servizio della società. E' questo lo...